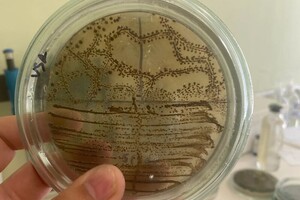
Поверенная Ангелина Сергеевна — Портфолио №12

Хорошо объясняет, крутые конспекты и легко находит общий язык)

Поверенная Ангелина Сергеевна
Репетитор по подготовке к ОГЭ по биологии
Паспорт не проверен
Дистанционно
О преподавателе
Образование
- Южный федеральный университет, биотехнология (с 2021 г.).
Основной род деятельности
Где проходят занятия
► Поверенная Ангелина Сергеевна проводит занятия территориально: Советский, а также дистанционно в онлайн-формате.
Как связаться
► Связаться с Поверенной Ангелиной Сергеевной можно за пару минут. Нажмите на кнопку «Связаться с репетитором» и заполните короткую форму.
Мы уточним несколько деталей, после чего репетитор получит вашу заявку и свяжется с вами для уточнения деталей.
Портфолио занятий
Услуги и цены
- Биология
- Биотехнология уточняется при заказе
- Ботаника уточняется при заказе
- ЕГЭ по биологии 1500 ₽ за час
- ОГЭ по биологии 1500 ₽ за час
Отзывы о Поверенной Ангелине Сергеевне
2 ученика уже оставили отзывы — прочитайте, прежде чем выбрать преподавателя.
Отзыв от 8 декабря 2024 Оценка: 5
Отзыв от 27 ноября 2024 Оценка: 5
Очень интересно проводились занятия, все хорошо слышно, красивые, разноцветные картиночки на слайдах, хорошая лекция, все понравилось👍💓